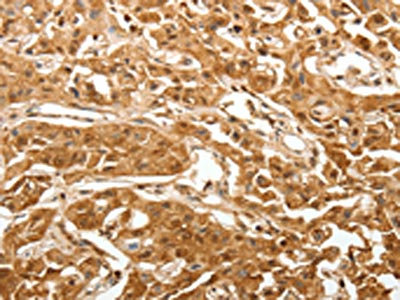

TXN Antibody
-
中文名稱:TXN兔多克隆抗體
-
貨號:CSB-PA791069
-
規格:¥1100
-
圖片:
-
The image on the left is immunohistochemistry of paraffin-embedded Human thyroid cancer tissue using CSB-PA791069(TXN Antibody) at dilution 1/40, on the right is treated with synthetic peptide. (Original magnification: ×200)
-
The image on the left is immunohistochemistry of paraffin-embedded Human lung cancer tissue using CSB-PA791069(TXN Antibody) at dilution 1/40, on the right is treated with synthetic peptide. (Original magnification: ×200)
-
Gel: 12%SDS-PAGE, Lysate: 40 μg, Lane 1-3: Hela cells, MCF7 cells, human liver cancer tissue, Primary antibody: CSB-PA791069(TXN Antibody) at dilution 1/600, Secondary antibody: Goat anti rabbit IgG at 1/8000 dilution, Exposure time: 20 seconds
-
-
其他:
產品詳情
-
Uniprot No.:
-
基因名:
-
別名:ADF antibody; ATL derived factor antibody; ATL-derived factor antibody; DKFZp686B1993 antibody; MGC61975 antibody; SASP antibody; Surface associated sulphydryl protein antibody; Surface-associated sulphydryl protein antibody; testicular tissue protein Li 199 antibody; THIO_HUMAN antibody; Thioredoxin antibody; thioredoxin delta 3 antibody; TRDX antibody; TRX 1 antibody; Trx antibody; TRX1 antibody; TXN antibody; TXN delta 3 antibody; TXN protein antibody; zgc:92903 antibody
-
宿主:Rabbit
-
反應種屬:Human,Rat
-
免疫原:Synthetic peptide of Human TXN
-
免疫原種屬:Homo sapiens (Human)
-
標記方式:Non-conjugated
-
抗體亞型:IgG
-
純化方式:Antigen affinity purification
-
濃度:It differs from different batches. Please contact us to confirm it.
-
保存緩沖液:-20°C, pH7.4 PBS, 0.05% NaN3, 40% Glycerol
-
產品提供形式:Liquid
-
應用范圍:ELISA,WB,IHC
-
推薦稀釋比:
Application Recommended Dilution ELISA 1:2000-1:10000 WB 1:1000-1:5000 IHC 1:50-1:200 -
Protocols:
-
儲存條件:Upon receipt, store at -20°C or -80°C. Avoid repeated freeze.
-
貨期:Basically, we can dispatch the products out in 1-3 working days after receiving your orders. Delivery time maybe differs from different purchasing way or location, please kindly consult your local distributors for specific delivery time.
-
用途:For Research Use Only. Not for use in diagnostic or therapeutic procedures.
相關產品
靶點詳情
-
功能:Participates in various redox reactions through the reversible oxidation of its active center dithiol to a disulfide and catalyzes dithiol-disulfide exchange reactions. Plays a role in the reversible S-nitrosylation of cysteine residues in target proteins, and thereby contributes to the response to intracellular nitric oxide. Nitrosylates the active site Cys of CASP3 in response to nitric oxide (NO), and thereby inhibits caspase-3 activity. Induces the FOS/JUN AP-1 DNA-binding activity in ionizing radiation (IR) cells through its oxidation/reduction status and stimulates AP-1 transcriptional activity.; ADF augments the expression of the interleukin-2 receptor TAC (IL2R/P55).
-
基因功能參考文獻:
- Data suggest that TSTD1 can utilize thioredoxin as an acceptor in the presence of thioredoxin reductase and NADPH. (TSTD1 = thiosulfate sulfurtransferase-like domain-containing 1 protein) PMID: 29348167
- Based on recent research, it has been reported that the modulation of the Trx/TrxR system may be considered as a new target in the management of the metabolic syndrome, insulin resistance, and type 2 diabetes, as well as in the treatment of hypertension and atherosclerosis. In this review evidence about a possible role of this system as a marker of the metabolic syndrome is reported. [review] PMID: 29327078
- By establishing that IL-4 is posttranslationally regulated by TRX-promoted reduction of a disulfide bond, our findings highlight a novel regulatory mechanism of the type 2 immune response that is specific to IL-4 over IL-13. PMID: 30104382
- TRX1 is an actionable castration-resistant prostate cancer therapeutic target through its protection against AR-induced redox stress. PMID: 29089489
- Trx-1 may be an important target for delaying oral malignant transformation, which provides a novel therapeutic strategy for the prevention and treatment of oral squamous cell carcinoma. PMID: 29328386
- Results found the mRNA level of TRX-1 was significantly decreased (p<0.005), while the mRNA levels of TBP-2, COX-2, and TNF-alpha were significantly increased in the placentas in preeclampsia when compared to the normal group. PMID: 29999276
- This study quantified the contribution of Trx reductase to the redox status of Trx, demonstrating that the redox profile of Trx is determined by the interplay between the elevation of intracellular redox potential and the reduction by Trx reductase and other endogenous molecules. PMID: 29509009
- We identified a novel Jab1-Trx axis that is a key cellular process in the pathobiologic characteristics of acute myeloid leukemia (AML-M5). Targeting the ROS/Jab1/Trx pathway could be beneficial in the treatment of AML-M5 PMID: 28270496
- study indicates that TRX levels cannot be used as a marker for Treatment Resistant Depression (trd) or repetitive transcranial magnetic stimulation treatment in TRD. In spite of this TRX levels have a positive correlation with language functions of the patients. PMID: 28442424
- The reducing system of PTEN was comprised of NADPH, thioredoxin reductase (TrxR1), and thioredoxin (Trx). PMID: 28774816
- Thioredoxin 1 modulates signaling mechanisms in the heart via its molecular targets, including transcription factors, microRNAs, histone deactylases, and protein kinases. (Review) PMID: 27993729
- The ratio of thioredoxin/Keap1 protein level may be useful for suggesting distant metastasis in colorectal cancer. PMID: 29053012
- Overexpression of NOS3 increased the levels and activities of proteins of the redoxin systems, Trx1, Grx1, TrxR1 and TxnIP, and the levels of signaling proteins (Akt1, pAkt1(-)Ser473, MapK, pMapK, Stat3, Fas). PMID: 28162284
- Increased serum thioredoxin concentrations are highly associated with trauma severity PMID: 28347674
- Plasma-TRX on day 1 was significantly increased in patients who later developed post-injury sepsis. In a logistic regression analysis including TRX, C-reactive protein, injury severity, massive transfusion, and admission blood pressure, TRX was the only variable independently associated with post-injury sepsis PMID: 28087409
- High TRX1 expression is associated with myocardial infarction. PMID: 26933812
- Data show that suberoylanilide hydroxamic acid (SAHA) induced apoptosis via the down-regulation thioredoxin1 (Trx1), which was regulated by microRNA miR-129-5p. PMID: 28667779
- Analysis of 25 independent cohorts with 5910 patients showed that Trx1 and TrxR1 were both associated with a poor patient prognosis in terms of overall survival, distant metastasis free survival and disease free survival. PMID: 26760912
- these findings demonstrate that Trx1 is a critical regulator of necroptosis that suppresses cell death by maintaining MLKL in a reduced inactive state. PMID: 28878015
- Study shows that TRX1 and APEX1 expressions are up regulated in new Multiple Sclerosis (MS) patients compared to controls and might be implicated in pathogenesis of the disease. PMID: 28844667
- CD40 activation resulted in down-regulation of Thioredoxin (Trx)-1 to permit ASK1 activation and apoptosis. Although soluble receptor agonist alone could not induce death, combinatorial treatment incorporating soluble CD40 agonist and pharmacological inhibition of Trx-1 was functionally equivalent to the signal triggered by mCD40L PMID: 27869172
- our findings identify the TXN-FOXO1-p300 circuit as the sensor and effector of oxidative stress in DLBCL cells PMID: 27132507
- Novel positive feedback loop between Trx-1 and S100P promotes colorectal cancer invasion and metastasis. PMID: 28483515
- Thioredoxin attenuates oxidized low-density lipoprotein induced oxidative stress in human umbilical vein endothelial cells by reducing NOX2-NOX4 activity. PMID: 28688762
- from the two catalytic cysteines of TRX1 the residue C32 is responsible for the high-affinity binding of TRX1 to the ASK1-TRX-binding domain in reducing conditions PMID: 27588831
- findings suggest that the up-regulated RRM1 and hTrx1 in colorectal cancer directly interact with each other and promote RR activity, resulting in enhanced DNA synthesis and cancer malignancy. PMID: 28411237
- Trx and its target proteins involved in redox signaling are critical for the control of cell fate such as cell survival and apoptosis [review] PMID: 27665998
- herefore, the length of treatment with Nrf2 activators and/or Trx-1 has first to be studied in more detail in cardiovascular disorders. Moreover, a combination of Nrf2 activators and Trx-1 should be investigated and taken into consideration. PMID: 27923281
- In an in vivo model of restenosis, which is characterized by oxidative stress, endothelial activation, and smooth muscle cell proliferation, Thioredoxin-1 protein levels are reduced in the endothelium of the carotids. APEX1 acts anti-apoptotic in endothelial cells. This anti-apoptotic effect depends on the first 20 amino acids of APEX1 PMID: 27835927
- Authors found that TXN was under expressed in both AML and ALL groups as compared to the control group. Also TXN expression level was negatively correlated with serum 8-OHdG and tail moment in both AML and ALL. PMID: 27158980
- Increased S-Trx and U-Trx concentrations, especially U-Trx/cr ratio, are closely associated with the severity of children hydronephrosis, substantializing Trx as a promising biomarker for the progression of children hydronephrosis PMID: 28111273
- TRX in postoperative serum may be a potential biomarker to predict development of postoperative delirium and cognitive dysfunction in elderly patients undergoing hip fracture surgery. PMID: 28093200
- Serum levels of thioredoxin and DJ-1 were significantly higher in non-small cell lung cancer patients; therefore, these may be utilized as novel diagnostic and prognostic biomarkers for non-small cell lung cancer PMID: 26334622
- Elevated plasma thioredoxin levels are correlated with the severity and poor prognosis in subarachnoid hemorrhage patients. PMID: 27000227
- Data show that the overexpression of thioredoxin1 (Trx1) attenuated apoptosis and reactive oxygen species (ROS) level in lung cancer cells. PMID: 26460805
- Based on its collective anti-oxidative, cytoprotective, and cytokine-like properties of TRX, TRX is likely to be involved in the optimal growth and maturation of ovarian follicles and responsiveness to hyperstimulation. PMID: 26536897
- change of serum levels of thioredoxin in patients with severe traumatic brain injury PMID: 26656445
- Serum TRX levels at admission were associated with stroke severity and lesion volumes. PMID: 25520003
- Results indicate that reduced Trx1 plays important protective roles against methyl methanesulfonate-induced DNA damage and cell death, suggesting that cell protection is regulated by the intracellular redox state. PMID: 26276860
- The results demonstrate that the antiproliferative effect of NO is hampered by Trx1 and Grx1 and support the strategy of weakening the thiolic antioxidant defenses when designing new antitumoral therapies. PMID: 26210445
- differential expression in children with allergic asthma PMID: 25979194
- identification of the novel interaction between Trx1 and AIF has provided opportunities to design and develop therapeutically relevant strategies that either promote or prevent this protein-protein interaction for the treatment of different disease PMID: 26119781
- Thioredoxin 1 mediates TGF-beta-induced epithelial-mesenchymal transition in salivary adenoid cystic carcinoma. PMID: 26325518
- In Jurkat cells exposed to ionizing radiatin (4 Gy), constitutively active Trx systems respond to restore cellular redox balance. After 16 hrs, Trx increases and rescues cells against IR-mediated damage. PMID: 26021764
- genetic variants of TXN and COMT have roles in regulating abdominal obesity PMID: 26329592
- Trx1 inhibition results in reactive oxygen species-induced apoptosis in Multiple myeloma cells, sensitizes Multiple myeloma cells to the NF-small ka, Cyrillicbeta inhibitors, and also induces apoptosis in bortezomib-resistant myeloma cells. PMID: 25945832
- thioredoxin is a remote ischemic preconditioning-induced factor in heart tissue of cardiosurgical patients. PMID: 25622749
- Plasma TRX levels of male patients in a manic episode were significantly lower than the controls. PMID: 25297388
- the overexpression and nuclear translocation of thioredoxin-1 (Trx-1) are closely associated with hypoxia-drug resistance through the regulation of the metabolism by the oxidative stress response to glycolysis. PMID: 25656992
- The crystal structure of fully oxidized thioredoxin shows a non-active Cys62-Cys69 disulfide bond in addition to the active Cys32-Cys35 disulfide. PMID: 26453009
顯示更多
收起更多
-
亞細胞定位:Nucleus. Cytoplasm. Secreted.
-
蛋白家族:Thioredoxin family
-
數據庫鏈接:
Most popular with customers
-
-
YWHAB Recombinant Monoclonal Antibody
Applications: ELISA, WB, IHC, IF, FC
Species Reactivity: Human, Mouse, Rat
-
Phospho-YAP1 (S127) Recombinant Monoclonal Antibody
Applications: ELISA, WB, IHC
Species Reactivity: Human
-
-
-
-
-